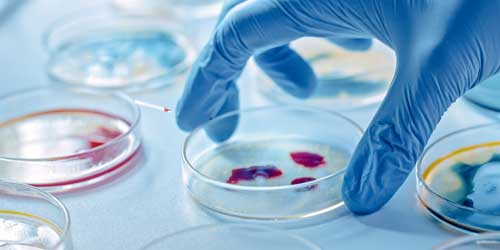

Microbiology Test Services at Assure Speciality Laboratory
At Assure Speciality Laboratory, we provide comprehensive microbiology testing services to help detect, identify, and monitor infections with precision and speed. Operating across Kolkata, Sonamukhi, and Purulia, our NABL-accredited facilities are equipped with advanced microbiological systems to support effective diagnosis and treatment planning.
Our microbiology department plays a pivotal role in the early detection and management of infectious diseases. With a focus on accuracy, sterile procedures, and scientific expertise, we ensure that each test we conduct contributes directly to better patient outcomes. Whether you are seeking a routine culture test or advanced pathogen identification, Assure Speciality Laboratory delivers reliable results that clinicians can trust.